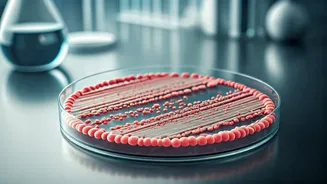
Typhoid Outbreak: Understanding the Risks & Staying Safe in India

Many Indians believe that eating home cooked food is enough to meet daily vitamin and mineral needs. The truth is different. A large number of people have hidden nutrient deficiencies without realising
it. These gaps often show up as tiredness, frequent illness, hair fall, or poor focus, but are rarely linked back to nutrition.
This article helps you spot early signs of common vitamin and mineral deficiencies, understand why they happen, and know what to do next. If you have been feeling “not quite right” despite eating regularly, this could explain why.
Why Vitamin and Mineral Deficiencies Are So Common Today
Vitamins and minerals are needed in small amounts, but they play a big role in how the body works every day. They support energy levels, immunity, bone strength, nerve health, skin, and metabolism.
According to data referenced by the Indian Council of Medical Research, a significant share of Indians do not meet recommended intake levels for nutrients like iron, vitamin D, vitamin B12, and calcium. Urban lifestyles have made this problem worse.
People spend more time indoors, rely on packaged foods, repeat the same meals daily, and deal with high stress. Over time, these habits quietly reduce micronutrient intake without affecting calorie intake.
Early Signs Your Body May Be Lacking Key Nutrients
Nutrient deficiencies do not appear overnight. The body gives small warning signs that are often ignored.
Constant Fatigue
Low iron, vitamin B12, or folate can reduce oxygen delivery and energy production. This often feels like daily tiredness that does not improve with rest.
Frequent Colds or Slow Healing
Deficiency of vitamin C, zinc, or vitamin D can weaken immune response, making you fall sick more often.
Hair Fall, Weak Nails, and Dull Skin
Low levels of biotin, iron, zinc, and vitamin A can affect hair strength, nail growth, and skin appearance.
Muscle Cramps or Bone Discomfort
Inadequate calcium, magnesium, or vitamin D may lead to cramps, joint stiffness, or bone pain, especially in people with low sun exposure.
Poor Focus and Mood Changes
B vitamin deficiencies, especially B6 and B12, can affect concentration, memory, and mood stability.
Common Vitamin and Mineral Deficiencies in India
Vitamin D
Despite plenty of sunlight,vitamin D deficiency is widespread. Indoor work, sunscreen use, and limited outdoor time reduce natural production. Low levels affect bones, muscles, and immunity.
Vitamin B12
Very common among vegetarians. Deficiency can cause fatigue, nerve issues, tingling sensations, and memory problems.
Iron
Iron deficiency is one of the most common nutritional problems in India, especially among women. It leads to low energy, breathlessness, and reduced stamina.
Calcium
Low calcium intake weakens bones and increases fracture risk with age. This risk rises further when vitamin D is also low.
Zinc
Zinc supports immunity and skin repair. Deficiency may cause frequent infections, slow wound healing, and skin issues.
Why a Regular Diet May Still Fall Short
Eating enough food does not always mean eating enough nutrients. Modern farming practices have reduced mineral content in soil. Cooking, reheating, and food storage also lower vitamin levels.
Many urban diets lack variety. Eating the same few foods daily meets calorie needs but not micronutrient diversity.
The World Health Organization recognises micronutrient deficiency as a global public health concern and stresses early identification and correction.
How to Check and Correct Nutrient Deficiencies
The first step is awareness. If symptoms repeat for weeks, nutrition should be considered as a cause.
Blood tests are the most reliable way to detect deficiencies, especially for vitamin D, vitamin B12, and iron. Based on results, doctors may suggest dietary changes or supplements.
Including a wide range of foods such as fruits, vegetables, pulses, nuts, seeds, dairy, and fortified foods helps improve intake. Consistency matters more than short term changes.
Simple Preventive Steps
● Spend some time outdoors regularly
● Add variety to daily meals
● Avoid skipping meals
● Get tested if symptoms persist
Why Preventive Nutrition Matters
Waiting for clear illness signs often means the deficiency is already advanced. Preventive nutrition helps maintain energy, immunity, bone strength, and skin health over time.
Addressing vitamin and mineral needs early is one of the simplest ways to support long term health, especially in fast paced urban lifestyles.
FAQs
How do I know if I have a vitamin deficiency? Common signs include fatigue, hair fall, muscle cramps, frequent infections, and poor focus. Blood tests confirm deficiencies.
Which vitamin deficiency causes constant tiredness? Iron and vitamin B12 deficiencies are common causes of ongoing fatigue.
Is vitamin D deficiency common in India? Yes. Limited sun exposure and lifestyle habits make it very common, even in sunny regions.
Can diet alone fix deficiencies? Mild gaps can improve with diet changes. Moderate or severe deficiencies often need medical guidance.
Disclaimer: This is a syndicated feed. The article is not edited by the FPJ editorial team.